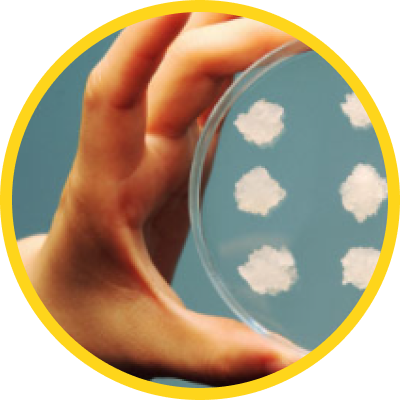
植物幹細胞分離

核心技術
革新幹細胞技術
我們精心從獨特植物中分離出極具活性的幹細胞,並在無污染的環境中培養,使我們能夠大規模生產高質量植物幹細胞。
全球獨家植物幹細胞技術
全球首創的植物幹細胞分離及培養技術,成功分離50年以上野山參的幹細胞,破解了160年以來的國際技術難題。項全球專利和擁有原料專利、技術專利和用途專利等包含內部的國際專利。
陳榮雨
科學家

全球獨家植物幹細胞技術
全球首創的植物幹細胞分離及培養技術,成功分離50年以上野山參的幹細胞,破解了160年以來的國際技術難題。項全球專利和擁有原料專利、技術專利和用途專利等包含內部的國際專利。
陳榮雨
科學家

韓國政府肯定的技術表彰

大韓民國技術獎
陳榮雨先生授予此韓國最高榮譽的產業技術表彰。

優秀中小企業家
優秀新產品開發獎

知識產權運營領域韓國產業部部長獎
授予知識產權保護及運營方面特別出色的團隊
特等獎
唯一獲得特等獎的團隊

韓國產業技術振興院
最佳產業化技術獎
各界專家給於植物幹細胞技術的評價

Gary Loake 教授
對於陳榮雨先生及其研究團隊技術的評價:這是世界第一次成功分離的植物幹細胞,這會成為生物學研究中非常重要的里程碑,在商業方面也具有著非常巨大的潛力,確實是非常尖端的研究成果。這件事情,到現在為止從來沒有成功過,對植物生物科技領域來說是意義極其重大的一次突破。

鄭永齊教授
對於陳榮雨先生及其研究團隊技術的評價:可以將中醫裡非常重要的植物的幹細胞分離,培養出來,然後應用在天然物醫藥品的開發當中,這對於中醫藥的科學化、世界化將帶來非常巨大的貢獻。

Robert Gallo 教授
對於陳榮雨先生及其研究團隊技術的評價:我曾經一直認為通過天然物進行科學化方面是有其不可避免的局限性的。但是通過陳及其團隊開發的植物幹細胞所擁有的優點,可以充分克服天然物的局限性,從而將其引向科學化的道路上來。目前可隨時邀請 Robert Gallo 教授共同參與進行利用植物幹細胞平台技術開發的愛滋病輔助治療用天然物新藥的臨床實驗。
各界專家給於植物幹細胞技術的評價

Gary Loake 教授
對於陳榮雨先生及其研究團隊技術的評價:這是世界第一次成功分離的植物幹細胞,這會成為生物學研究中非常重要的里程碑,在商業方面也具有著非常巨大的潛力,確實是非常尖端的研究成果。這件事情,到現在為止從來沒有成功過,對植物生物科技領域來說是意義極其重大的一次突破。
真正的植物幹細胞CMC (形成層細胞)
CAT 活性:
戰勝壓力的力量


長期培養:
不朽性


大量的、活躍的粒線體活性:
強有力的能量供應


細胞聚集程度:
聚集成大小不一的團塊


CAT 活性:
戰勝壓力的力量


長期培養:
不朽性


大量的、活躍的粒線體活性:
強有力的能量供應


細胞聚集程度:
聚集成大小不一的團塊


目前已擁有數十種植物的幹細胞株
將來還可以從3000種珍貴草藥中分離更多種植物幹細胞










大量培養植物幹細胞流程
植物幹細胞分離
培養皿

小規模倍增
3公升生物反應器

大規模倍增
250公升生物反應器

有效物質生產
3,000公升生物反應器

商業化生產